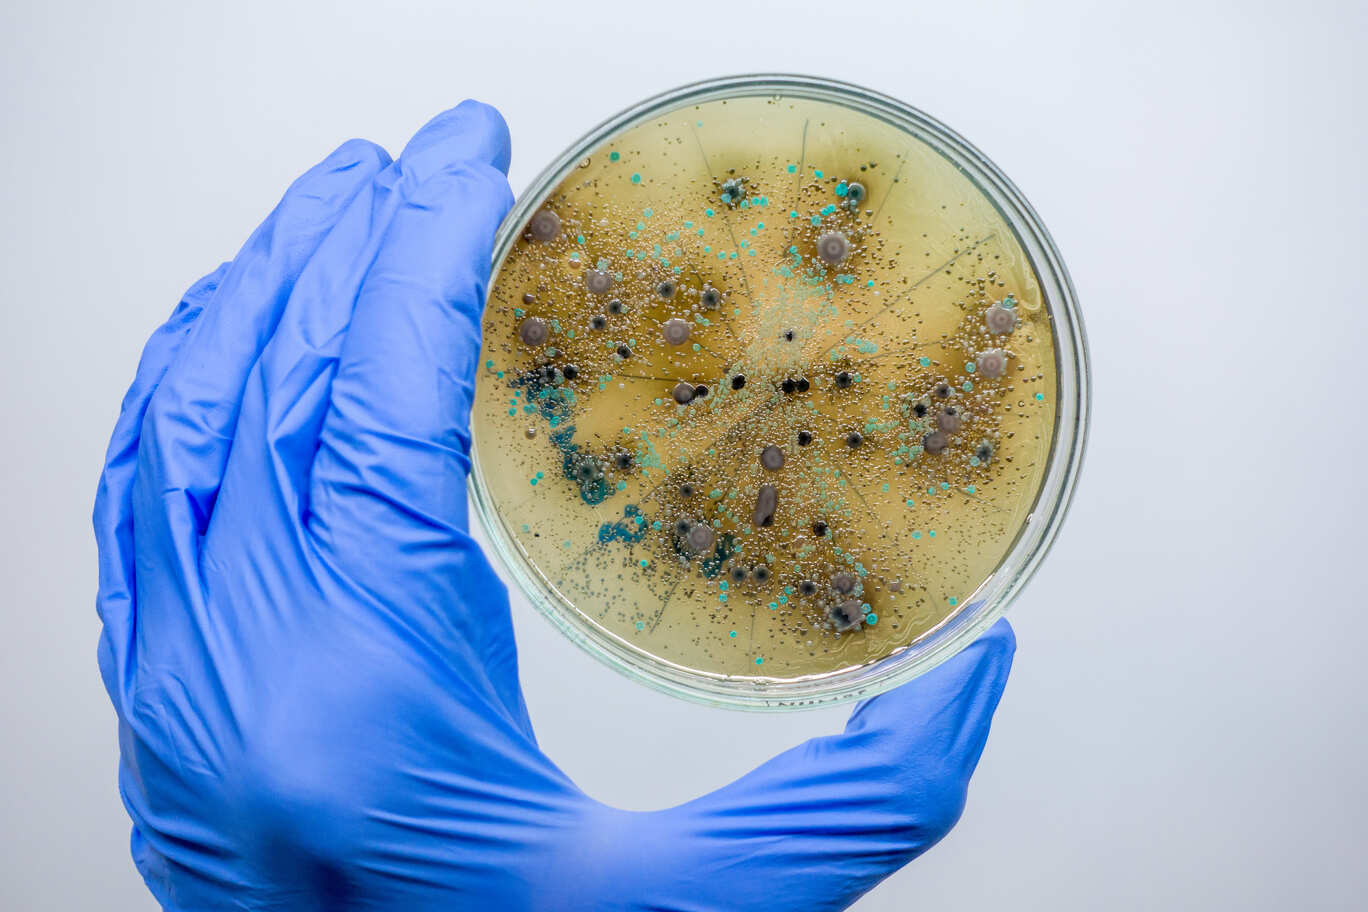
Российские биологи нашли способ тестировать лекарства без животных

В работе исследовались эффекты агонистов и блокаторов адренорецепторов — ключевых мишеней многих препаратов, применяемых в кардиологии, неврологии и анестезиологии.
«Оказалось, что у инфузорий можно надежно фиксировать реакцию на такие вещества: изменения подвижности, направления движения и чувствительности к стимуляции. Эти эффекты оказались сопоставимыми с теми, что наблюдаются в экспериментах на тканях млекопитающих», — отмечается в сообщении вуза.
Первичный скрининг соединений, когда исследователи отбирают кандидатов для дальнейших испытаний, — один из самых дорогих этапов при разработке лекарств. Для этого традиционно используют культуры клеток или животных моделей, что связано с высокими затратами и этическими ограничениями.
Инфузории — одноклеточные организмы. Они чувствительны к воздействию химических веществ и демонстрируют воспроизводимые изменения поведения при контакте с фармакологическими агентами. «Использование инфузорий помогает снизить стоимость исследований и обойти ограничения, связанные с биоэтикой при работе с позвоночными животными», — подчеркивает научный сотрудник кафедры высшей нервной деятельности биологического факультета МГУ Глеб Груздев.
Система может использоваться не только в фармакологических лабораториях, но и в образовательном процессе.
Результаты исследования опубликованы в журнале Clinical Case Reports and Reviews.